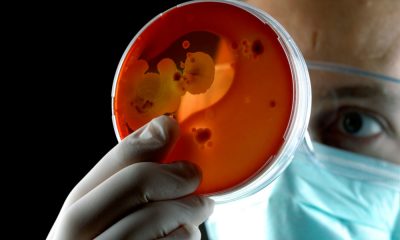
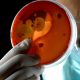

El presidente francés, Emmanuel Macron, intenta frenar el movimiento de los “chalecos amarillos”, que nació en protesta por el alza de los combustibles y la pérdida...

Científicos de la NASA encontraron en el baño de la Estación Espacial Internacional (EEI) una cepa mutada del Enterobacter bugandesis resistente a los antibióticos, como la...


El presidente Donald Trump indicó que su hija Ivanka y el vicepresidente Mike Pence asistirán el sábado a la toma de protesta del presidente electo Andrés...


Seis hoteles yucatecos decidieron ampararse contra la Comisión Reguladora de Energía (CRE) por el alto costo del servicio de electricidad, que en los últimos meses se...


Ana Méndez Petterson, directora general del Instituto de Historia y Museos de Yucatán (IHMY), manifestó que a través de programas de extensión y de educación para...


Pobladores de Hunucmá e Izamal participaron el día de ayer en la Consulta Nacional de 10 Programas Prioritarios, convocada por Andrés Manuel López Obrador. En Hunucmá,...


Más de 100 personas resultaron heridas en el presunto ataque químico contra barrios residenciales de la ciudad de Alepo, Siria. El Ministerio de Defensa de Rusia...


Los incendios forestales que cobraron la vida de al menos 85 personas se encuentran ya bajo control, informaron las autoridades estadounidenses. Según el Departamento Forestal y...


Este domingo más de 500 personas resultaron heridas por el terremoto de 6.4 grados en la escala Ritcher, que afectó a la provincia de Kermanshah. Mahmudreza...


De acuerdo con la más reciente encuesta nacional realizada por El Universal, la calificación otorgada por los ciudadanos a su labor como presidente electo disminuyó de...